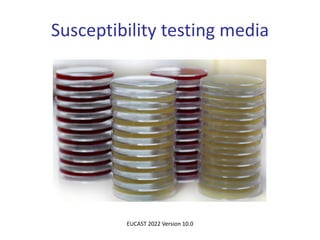
Susceptibility testing media
EUCAST 2022 Version 10.0
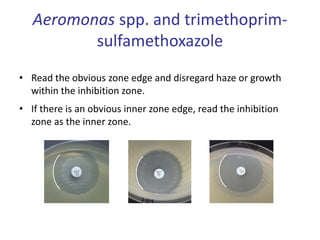
Aeromonas spp. and trimethoprim-
sulfamethoxazole
• Read the obvious zone edge and disregard haze or growth
within the inhibition zone.
• If there is an obvious inner zone edge, read the inhibition
zone as the inner zone.

The document presents detailed guidelines on the EUCAST disk diffusion method for antimicrobial susceptibility testing, covering media preparation, inoculum preparation, and incubation conditions. It specifies the use of Mueller-Hinton agar for both non-fastidious and fastidious organisms, with specific recommendations for different bacteria types. The document emphasizes the importance of accuracy in measuring inhibition zones and the conditions for maintaining the quality of agar plates and antimicrobial disks.